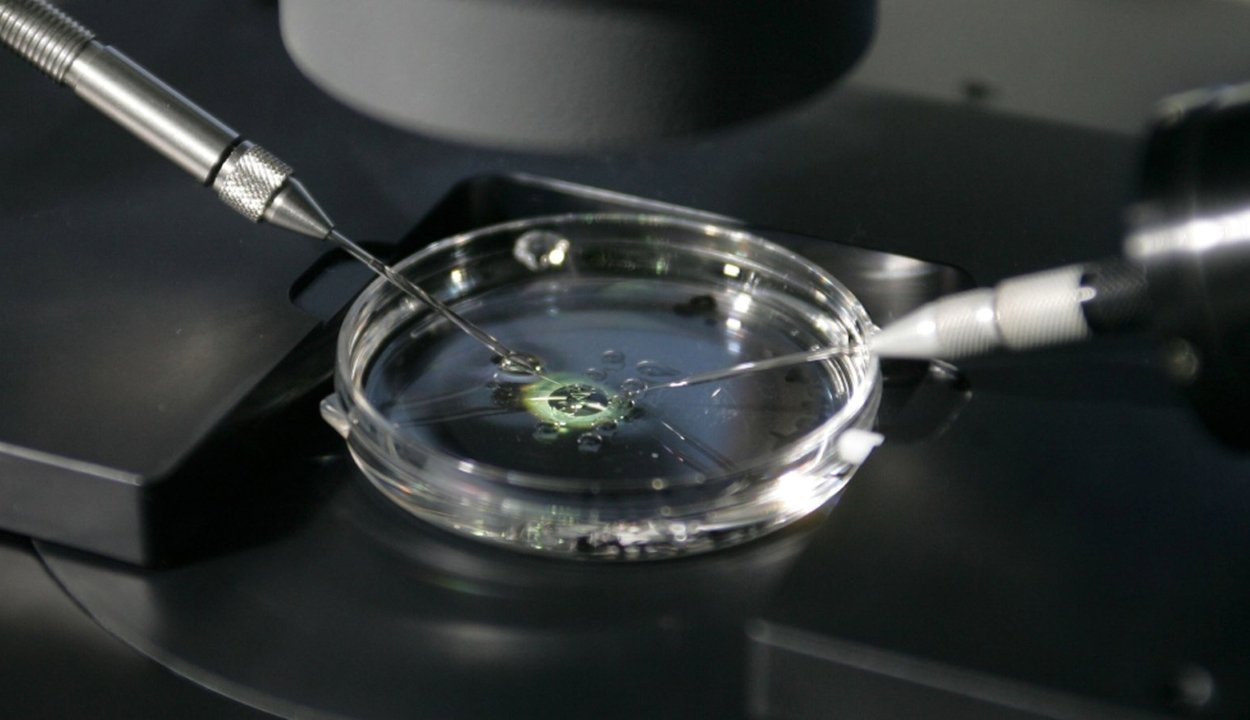

Az érintettek már évek óta gyanították, hogy a Rotterdam mellett, Barendrechtben 1980 és 2009 között saját meddőségi klinikát működtető férfi nem anonim donortól származó spermát, hanem saját ondósejtjeit használta a megtermékenyítéshez, de egy holland bíróság csak februárban kötelezte az özvegyet arra, hogy bocsássa rendelkezésre a DNS-vizsgálatokhoz a férfi egykori személyes tárgyait. A vizsgálatokat a nijmegeni Canisius-Wilhelmina kórházban végezték.
Jan Karbaat még életében elismerte, hogy mintegy 60 gyermeknek lehet az apja, de amíg élt, nem járult hozzá a DNS-teszthez. Az orvos özvegye is mindvégig elutasította az együttműködést az érintettekkel, és továbbra is tagad minden személyes felelősséget, tartva a hagyatéki perek sokaságától.
Karbaat klinikáját 2009-ben bezárták különféle szabálytalanságok miatt.
(MTI)

Csíkszék
Csíkszék












 Látogatottsági adatok
Látogatottsági adatok
szóljon hozzá!